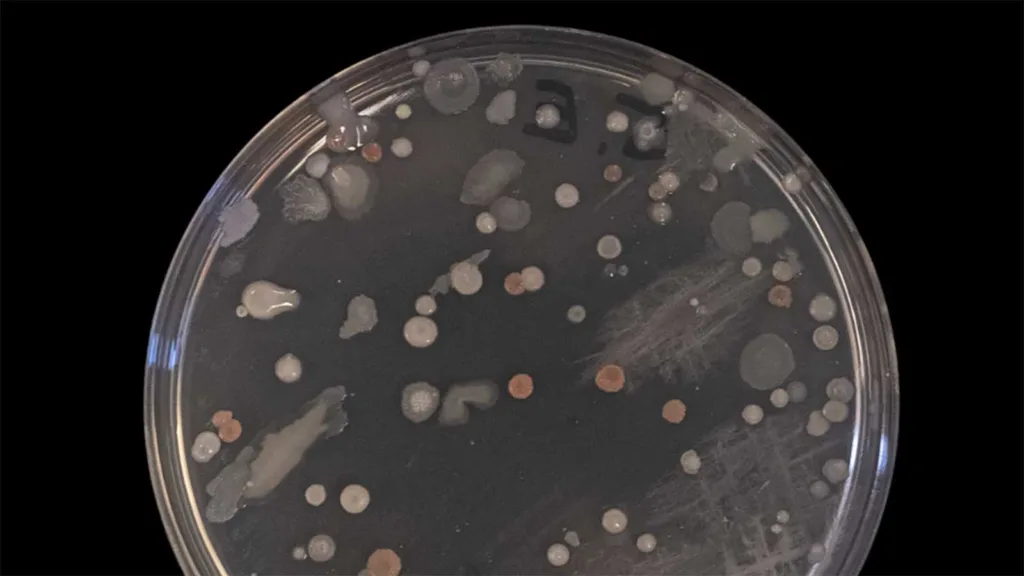

Okända bakteriefällorna i din bil avslöjade. Myten om att bilen är smutsigare än toalettsitsen visar sig vara sann.
– Alla testade platser var lika med eller översteg den bakteriella kontaminering man sannolikt hittar i toalettstolen och på spolknappen, säger doktor Jonathan Cox vid Aston University.
Din bil är betydligt mer kontaminerad med bakterier än du tror. Brittiska forskare från Aston University har tillsammans med ScrapCarComparison genomfört en noggrann studie av fem begagnade bilar i olika åldrar. Deras chockerande upptäckt var att nästan alla ställen i bilen innehåll en betydligt högre bakterimängd än toaletter och spolknappar som de samtidigt tog prov på.
En forskargrupp från Aston University under ledning av doktor Jonathan Cox, universitetslektor i mikrobiologi tog prover med en steril bomullspinne på sex olika platser i bilarna. De placerade sedan proverna på en bakterieodling som fick stå i ett värmeskåp i 37° Ci 24 timmar. Upptäcken kommer chocka många som har bacillskräck.
– Bilarna som testades var mycket kraftigt förorenade – och inte bara med bakterier vi förväntar oss att hitta, säger doktor Jonathan Cox till ScrapCarComparison.
Många hade förväntat sig att ratten skulle vara värst. Men istället var det platsen där vi förvarar våra matvaror som stack ut rejält i studien. Bagageutrymmet visade sig vara den överlägset mest kontaminerade platsen i bilen. Dessutom hade samtliga fem bilar avföringsbakterier i kofferten. Totalt hittades 1425 bakterier i bagageproverna.
– Det är ofta i bagageutrymmet vi lägger våra matvaror när vi går till mataffären – och med en minskad användning av bärkassar finns det en mycket större risk att kasta lösa föremål i bagageutrymmet på en bil på vägen hem. Med detta i åtanke bör vi vara uppmärksamma på att minska risken med denna mat genom att se till att rengöra all frukt, grönsaker eller andra produkter ordentligt innan vi äter dem, säger Jonathan Cox.

Näst värst var förarsätena. Även där fanns det avföringsbakterier på samtliga bilar som testades. Forskarna kunde identifiera 649 bakterier. Ratten var däremot betydligt renare än forskarna hade förväntat sig. Där hittades 146 bakterier, bara en tiondel så många som i bagaget. En förklaring kan vara covid-19-pandemin som har gjort att många använder handsprit, och kanske har spritat ratten. Däremot var växelspaken betydligt smutsigare än ratten, vilket gör att slutsatsen är något tvetydig.
Bilarna som undersöktes var mellan två och 17 år gamla. Det visade sig att mängden bakterier och bilens ålder hade ett tydligt samband. Det verkade inte hjälpa att de städades. Den som vill ha en begagnad bil fri från bakterier bör därför överväga att desinficera bilen, eller helt enkelt köpa en ny bil. Men enligt forskarna behöver vi inte vara alltför oroliga. De flesta bakterierna de hittade i bilarna är tämligen ofarliga.
Det kan dock vara värt att tänka på att inte lägga matvaror löst i bagageutrymmet då forskarna hittade avföringsbakterier där. Du bör också överväga att inte äta upp mat som du tappat på bilsätet som också kan innehålla e-coli-bakterier.
Forskarna råder bilägare att inte bara fokusera på utseendet när de tvättar och städar sina bilar. Det kan vara en god idé att rengöra kontaminerade delar av bilen med ett antibakteriellt rengöringsmedel som sprayas på en trasa. Att schamponera sätena regelbundet kan vara en god idé. Samtidigt gäller det att se upp då bilarnas plaster kan vara känsliga för olika kemikalier.
Områdena i våra bilar med mest bakterier
- Bagageutrymmet – 1 425 bakterier identifierade
- Förarsätet – 649 bakterier identifierade
- Växelspak – 407 bakterier identifierade
- Baksätet – 323 bakterier identifierade
- Instrumentpanel – 317 bakterier identifierade
- Ratt – 146 bakterier identifierade
Bakterierna som hittades i bilarna
E-coli (Escherichia coli)
Kommer vanligtvis från tarmarna och de flesta är ofarliga. Men vissa e-coli-bakterier kan orsaka matförgiftning till exempel om du tappar mat på ett kraftigt förorenad säte och sedan äter den. Även bagageutrymmet kan utgöra en risk om du förvarar maten utan skydd.
Pseudomonas
En vanlig bakterie som förekommer på många ställen som jord, vatten, hud. Men den orsakar allt fler infektioner och är resistent mot många antibiotika.
Bacillus
En bakterie som finns i mag-tarmkanalen hos både människor och idisslande djur. Den är tämligen ofarlig.
Staphylococcus epidermidis
Det är en hudbakterie som finns hos alla människor. Den är oftast ofarlig men kan orsaka infektioner för den som har nedsatt immunförsvar.
Staphylococcus epidermidis
En bakterie som återfinns i övre luftvägarna, främst näsan. Kan orsaka hosta och nysningar. Vissa varianter har börjat bli resistenta mot antibiotika.
Jästsvampar (Rhodotorula mucilaginosa)
Jästsvampar som finns naturligt i vår miljö och i de flesta fall är helt ofarliga.
Rhodotorula
Jäst i miljön (jord, vatten, mjölk, fruktjuice etc.) – kan i sällsynta fall orsaka infektioner hos personer med nedsatt immunförsvar.
Testade bilar
- Bil 1: Peugeot 307-SW; 17 år gammal; djur; köpt begagnad med en tidigare ägare.
- Bil 2: VW Golf; 5 år gammal; djur och barn; köpt som begagnad bil med två tidigare ägare.
- Bil 3: Ford Focus; 13 år gammal; djur och barn; köpt begagnad med en tidigare ägare.
- Bil 4: Honda Jazz; 9 år gammal; djur och barn; köpt som begagnad bil med två tidigare ägare.
- Bil 5: Peugeot 308; 2 år gammal; köpt begagnad med en tidigare ägare.
LÄS MER:
Maths Nilsson är grundare av Carup.















